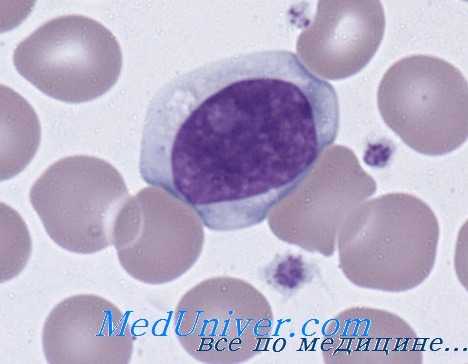
моноцитоз

Регуляторные механизмы комплемента. Защитные функции комплемента
Добавил пользователь Cypher Обновлено: 16.12.2025
Иммунная система работает, чтобы уничтожить антигены, используя иммунные клетки и особые молекулы. Завершение иммунного ответа происходит, когда антиген изолирован или уничтожен. Память о нем сохраняется для быстрой реакции при новой встрече.
Антитела
Антитела – главный молекулярный компонент гуморального иммунного ответа. Они секретируются плазматическими клетками, образованными из В-лимфоцитов. Распознают последовательности белков, полисахаридов и других структур конкретного антигена, точно соединяются с ним по поверхностным свойствам, подходя как ключ к замку. Благодаря наличию сходных структур, один и тот же вид антител перекрестно реагирует на разные антигены. По строению антитела представляют собой иммуноглобулины Ig нескольких классов.
Иммуноглобулин М IgM – первый вид антител, который формируется после встречи с новым антигеном. Циркулируя по крови, он связывает антиген и активирует комплемент, облегчая фагоцитоз. Каждый IgM связывает много антигенов, но эти связи непрочные. Он неидеально подходит к замку и больше похож на грубую заготовку ключа, поэтому часто бывают перекрестные реакции с другими антигенами.
Иммуноглобулин G IgG является наиболее распространенным иммуноглобулином в крови, но обнаруживается и в тканях. Это единственный иммуноглобулин, который проходит через плацентарный барьер во время беременности, обеспечивая иммунную защиту новорожденного в первые месяцы жизни. Для его формирования в первичном иммунном ответе требуется несколько дней и активная поддержка Т-лимфоцитов. Этот ключик более отточенный, причем чем больше проходит времени, тем идеальнее он подходит к замку. Свойство «идеальности» связывания с антигеном называется авидность. Именно поэтому при повторной встрече, высокоавидные IgG действуют более эффективно и быстро.
Иммуноглобулин А IgA присутствует в небольшом количестве в крови, но работает преимущественно в виде секреторного sIgA на поверхностях слизистых оболочек и в секретах (слюна, слезная жидкость, молозиво).
Иммуноглобулин D IgD связан с IgM на поверхности молодых В-лимфоцитов. Его уровни в крови очень низкие, а функция не известна.
Иммуноглобулин Е IgE присутствует в крови, на слизистых оболочках дыхательных путей и желудочно-кишечного тракта в небольшом количестве. Он обладает высоким сродством к рецепторам тучных клеток и базофилов. Если антиген взаимодействует с IgE на поверхности этих клеток, происходит их дегрануляция. Это выход содержимого гранул клеток, вызывающих острую аллергическую воспалительную реакцию.
Система комплемента
Система комплемента – это особый тип молекул (белки, ферменты и их предшественники), которые помогают в иммунном ответе. Система комплемента связывает врожденный и приобретенный иммунитет, т.к. участвует в фагоцитозе, выработке антител, уничтожении чужеродных клеток.
Компоненты системы комплемента выполняют множество функций: стимулируют хемотаксис (направленное движения лейкоцитов к антигенам), запускают дегрануляцию тучных клеток независимо от связывания антигена с IgE, помогают фагоцитирующим клеткам связывать антигены (опсонизация) и многое другое. Компоненты комплимента обозначаются буквой С и цифрой, обозначающей очередность их открытия (от С1 до С9), просто буквами (фактор B, фактор D) или имеют название (пропердин).
Активация комплимента происходит под действием иммунных комплексов, образованных связками антиген-антитело, либо же в ответ на крупные антигены и белки острой фазы.
Врожденный и приобретенный дефицит компонентов комплемента существенно снижает устойчивость организма к инфекционным агентам.
Белки воспаления
Воспаление – это местная и общая реакция организма в ответ на раздражитель. Его цель устранить причину повреждения и восстановить ткань в месте повреждения. Раздражители бывают механическими (травма), химическими (ожог, кислоты), инфекционными (бактерии, вирусы и их токсины), иммунными (комплексы антиген-антитело, комплемент).
Белки острой фазы – белки плазмы, уровень которых резко повышается или, в некоторых случаях, понижается при ответе на поражение тканей. Образуются они преимущественно в печени под действием высоких уровней ИЛ-1, ИЛ-6, ФНО-альфа в крови. Наиболее резко повышаются уровни:
Альфа-1 кислого гликопротеина
Сывороточного Р-компонента амилоида
Они повышаются через несколько часов после начала воспаления, способствуют активации комплемента, облегчают фагоцитоз, помогают ограничивать повреждение тканей, повышают сопротивляемость организма к инфекциям, способствуют заживлению тканей и прекращению воспаления. Альфа-1-кислый гликопротеин также является транспортным белком.
К белкам острой фазы воспаления относят фибриноген, ферритин, гаптоглобин, церулоплазмин и другие белки. Например, фибиронген помимо основной функции формирования тромба и остановки кровотечения, которые способствуют заживлению тканей, способен также усиливать фагоцитоз. Уровни фибриногена увеличиваются при воспалении и являются основной причиной повышения скорости оседания эритроцитов (СОЭ) в анализах.
Измерение уровней белков острой фазы указывают на воспаление, инфекцию или травму, но не помогают определить причину их возникновения.
В крови содержится еще много других молекулярных компонентов, которые участвуют так или иначе в воспалении и иммунном ответе. Дисбаланс их работы способствует либо чрезмерному ответу с поражением собственных тканей, развитием аутоиммунной патологии, либо наоборот, слабому ответу с развитием хронического воспалительного процесса.
Регуляторные механизмы комплемента. Защитные функции комплемента
Моноцитоз
Абсолютное количество моноцитов в крови зависит от возраста. Учитывая роль моноцитов в представлении антигенов, секреции цитокинов и поглощении микроорганизмов, неудивительно, что увеличение числа этих клеток наблюдается при многих клинических состояниях. Чаще всего моноцитоз развивается в процессе восстановления после миелосупрессивной химиотерапии, опережая нормализацию числа нейтрофилов. Нередко он служит признаком риккетсиоза, острой бактериальной, вирусной или протозойной инфекции и встречается при некоторых формах хронической нейтропении, а также после удаления селезенки.
Выраженный постоянный моноцитоз наблюдается при хронических воспалительных процессах, включая предлейкоз, хронический миелолейкоз, лимфомы, а иногда и болезнь Ходжкина.
Лимфоцитоз
Самые частые причины лимфоцитоза — острые вирусные заболевания. Поскольку большинство лимфоцитов крови составляют Т-лимфоциты, лимфоцитоз — нормальная реакция при очень многих вирусных инфекциях. При инфекционном мононуклеозе В-лимфоциты поражаются вирусом Эпштейна-Барр, а Т-лимфоциты реагируют на вирусные антигены, представляемые В-клетками. В результате образуются атипичные лимфоциты — крупные вакуолизированные клетки. К другим вирусным инфекциям, сопровождающимся лимфоцитозом, относятся ЦМВ и вирусный гепатит.
Длительный лимфоцитоз наблюдается и при хронических бактериальных инфекциях — туберкулезе и бруцеллезе, а также примерно у 25 % детей, заболевших коклюшем до 6-месячного возраста. Среди эндокринных заболеваний, сопровождающихся лимфоцитозом, следует упомянуть тиреотоксикоз и первичную надпочечниковую недостаточность. Длительный или выраженный лимфоцитоз указывает на острый лимфолейкоз.
Комплементом первоначально называли неспецифический термолабильный фактор, присутствующий в сыворотке крови и необходимый для лизирования бактерий специфическими антителами. В дальнейшем выяснилось, что этот фактор состоит из нескольких компонентов. Первые четыре из них, пронумерованные в порядке открытия, в настоящее время называют компонентами классического пути активации комплемента. К несчастью Для студентов и врачей впоследствии оказалось, что они присоединяются к иммунному комплексу в ином порядке, а именно С1423.
За исключением этого путающего обстоятельства, комплемент представляет собой логичную, точнейшим образом сбалансированную и реагирующую на многие воздействия систему, имеющую важнейшее значение для клинических проявлений воспалительных реакций.
Различают классический путь активации этой системы, путь с участием маннозосвязывающего лектина (MCJI), и альтернативный путь; проявление полной активности этих путей зависит от их взаимодействия друг с другом. На каждом пути образуется мембраноатакующий комплекс (С5b6789). В настоящее время выяснена роль восьми сывороточных и четырех мембранных регуляторных белков.
Охарактеризованы серозный регуляторный белок и семь мембранных рецепторов, связывающих компоненты комплемента или их фрагменты. На долю 24 компонентов и регуляторов комплемента приходится около 15% глобулиновой фракции сыворотки крови. Концентрации сывороточных компонентов комплемента изменяются с возрастом; для новорожденных характерна от небольшой до умеренной недостаточность всех компонентов системы комплемента.
За исключением первых четырех компонентов, номенклатура системы комплемента логична и подчиняется нескольким правилам. Фрагменты компонентов, образующиеся при расщеплении другими компонентами системы, действующими как ферменты, обозначаются строчными буквами «а», «b», «с», «d» или «е». За исключением фрагментов С2, меньший осколок, попадающий в окружающую жидкость, обозначается буквой «а», а более крупная часть молекулы, остающаяся связанной с другими компонентами или какой-то частью иммунного комплекса, — буквой «b» (например, С3а и С3b).
Компоненты альтернативного пути, В и D, обозначаются прописными буквами, как и регуляторные белки I и Н, которые ингибируют и тот, и другой путь. С3 и особенно его более крупный фрагмент С3b являются компонентами как классического, так и альтернативного пути.
Комплемент — это система взаимодействующих белков. Функция всей системы зависит от последовательного, каскадного взаимодействия ее отдельных компонентов. Активация каждого компонента, за исключением первого, требует активации предыдущего компонента(ов) каскада. Взаимодействия происходят по трем направлениям (путям). Последовательность классического пути: антиген-антитело-С 142356789; последовательность МСЛ-пути: микробный маннан-МСЛ/ МСЛ-ассоциированные протеазы 1 и 2-С42356789; последовательность альтернативного пути: активатор-С3bBD-С356789. Антитела активируют альтернативный путь, но его активация на соответствующей поверхности может происходить и в отсутствие антител.
Классический и альтернативный пути взаимодействуют друг с другом через их способность активировать компонент С3.
Активация первых компонентов комплемента (С1423) приводит к образованию на поверхности иммунного комплекса или клетки ряда активных ферментов — C1, C42 и С432. Эти ферменты расщепляют и активируют следующий компонент последовательности. Взаимодействие компонентов С5b, С6, С7, С8 и С9 осуществляется не ферментативным путем, а за счет изменений конфигурации молекул.
Без регуляторных механизмов, действующих на многих этапах, система комплемента оказалась бы неэффективной; неограниченное расходование ее компонентов могло бы привести к тяжелым, потенциально смертельным повреждениям клеток и тканей организма. На первом этапе ингибитор С1 блокирует ферментативную активность Clr и Cls и, следовательно, расщепление С4 и С2. Активированный С2 сохраняется лишь короткое время, и его относительная нестабильность ограничивает время существования С42 и С423. Активирующий СЗ фермент альтернативного пути, С3bВb, также обладает коротким временем полувыведения, хотя связывание пропердина ферментным комплексом продлевает время существования комплекса.
В сыворотке присутствует инактиватор анафилатоксинов — фермент, отщепляющий N-концевой аргинин от С4а, С3а и С5а и тем самым резко снижающий их биологическую активность. Фактор I инактивирует C4b и С3b, фактор Н ускоряет инактивацию С3b фактором I, а аналогичный фактор, С4-связывающий белок (С4-сб), ускоряет расщепление С4b фактором I. Три конституциональных белка клеточных мембран — РК1, мембранный кофакторный белок и фактор, ускоряющий распад (ФУР) — разрушают С3- и С5-конвертазные комплексы, формирующиеся на этих мембранах.
Другие компоненты клеточных мембран — ассоциированные белки (среди которых наиболее изучен CD59) — могут связывать С8 или С8 и С9, что препятствует встраиванию мембраноатакующего комплекса (С5b6789). Некоторые белки сыворотки крови (среди которых наиболее изучены протеин S и кластерин) блокируют присоединение к клеточной мембране комплекса С5b67, связывание им С8 или С9 (т. е. образование полноценного мембраноатакующего комплекса) или как-то иначе препятствуют образованию и встраиванию этого комплекса.

Защитная роль комплемента
Нейтрализация вирусов антителами усиливается С1 и С4 и еще больше возрастает при фиксации С3b, образующегося по ходу классического или альтернативного пути. Таким образом, комплемент приобретает особую важность на ранних стадиях вирусной инфекции, когда количество антител еще невелико. Антитела и комплемент ограничивают инфектив-ность по крайней мере некоторых вирусов и за счет образования типичных комплементных «дыр», видимых при электронной микроскопии. Взаимодействие Clq с его рецептором опсонизирует мишень, т. е. облегчает ее фагоцитоз.
С4а, С3а и С5а фиксируются тучными клетками, которые начинают секретировать гистамин и другие медиаторы, приводя к расширению сосудов и характерным для воспаления отеку и гиперемии. Под влиянием С5а моноциты выделяют ФНО и ИЛ-1, усиливающие воспалительную реакцию. С5а — основной хемотактический фактор для нейтрофилов, моноцитов и эозинофилов, способных фагоцитировать микроорганизмы, опсонизированные С3b или продуктом его расщепления iC3b. Дальнейшая инактивация связанного с клеткой С3b, приводящая к появлению C3d, лишает его опсонизирующей активности, но способность его связывания с В-лимфоцитами сохраняется. Фиксация С3b на клетке-мишени облегчает ее лизис NK-клетками или макрофагами.
Связывание С3b с нерастворимыми иммунными комплексами солюбилизирует их, так как С3b, по-видимому, разрушает решетчатую структуру комплекса антиген-антитело. Одновременно появляется возможность взаимодействия этого комплекса с рецептором С3b (РК1) на эритроцитах, которые переносят комплекс в печень или селезенку, где он поглощается макрофагами. Этот феномен частично объясняет развитие сывороточной болезни (болезни иммунных комплексов) у лиц с недостаточностью С1, С4, С2 или С3.
Комплемент объединяет системы врожденного и приобретенного (специфического) иммунитета. Прикрепление С4b или С3b к иммунным комплексам способствует связыванию последних с АПК (макрофагами, дендритными клетками и В-лимфоцитами). Присоединение C3d к антигену обеспечивает его связь с РК2 на В-лимфоцитах. Это примерно в 10 000 раз снижает количество антигена, необходимое для образования антител.
Нейтрализация эндотоксина in vitro и защита экспериментальных животных от его летальных эффектов требуют присутствия действующих на поздних стадиях компонентов комплемента, начиная с С6. Наконец, в результате активации всей последовательности комплемента происходит лизис инфицированных вирусом или опухолевых клеток и большинства микроорганизмов. Бактерицидная активность комплемента, по-видимому, не играет существенной роли в иммунитете. Исключение составляет гонококковая инфекция, развивающаяся у больных с недостаточностью поздних компонентов комплемента.
Классический путь активации комплемента
Классический путь активации комплемента начинается после взаимодействия антиген-антитело с присоединения С1 (через Clq) к Fc-фрагменту — не связывающей антиген части молекулы антитела. Образовавшийся тройной комплекс при этом меняет свою конфигурацию, компонент Cls превращается в активный фермент С1-эстеразу.
Фиксировать Clq могут не только антитела, но и С-реактивный белок, реагирующий с углеводом микробной стенки. Уровень этого белка возрастает при некоторых воспалительных процессах. Таким образом, классический путь активации комплемента может начинаться и в отсутствие антител. К агентам, способным прямо (без участия антител) активировать С1, принадлежат некоторые бактерии, Mycoplasma, вирусные РНК, кристаллы мочевой кислоты, липидный компонент А бактериального эндотоксина и продукты тканевого распада (апоптозные пузырьки и митохондриальные мембраны).
МСЛ-путь активации комплемента. МСЛ, принадлежащему к коллектиновому семейству углеводсвязывающих белков, отводят важную роль в формировании врожденного неспецифического иммунитета; он обладает структурной гомологией с Clq. При взаимодействии с двумя МСЛ-ассоциированными сериновыми протеазами (МАСП) МСЛ связывается с остатками маннозы на поверхности бактерий и грибов и, подобно C1s, расщепляет С4 и С2, активируя тем самым каскад комплемента.

Кининоподобный пептид, отщепляющийся от С2, непосредственно влияет на посткапиллярные венулы, повышая их проницаемость и вызывая отек тканей. Пептид С4а обладает слабой анафилатоксиновой активностью и, реагируя с тучными клетками, вызывает секрецию химических медиаторов аллергических реакций немедленного типа, включая гистамин. Позднее образующиеся на этом пути С3а и С5а представляют собой более активные анафилатоксины, а С5а, кроме того, играет роль хемоаттрактанта.
Фиксация С4b создает возможность присоединения комплекса к нейтрофилам, макрофагам, В-лимфоцитам, дендритным клеткам и эритроцитам.
На следующем этапе происходит расщепление С3 с образованием С3b. Среди всех компонентов комплемента С3 присутствует в наибольшей концентрации, и его активация — важнейший этап каскадного процесса. Расщеплению С3 способствует С3-конвертаза классического (С142) или альтернативного (С3bВb) пути. Фиксация С3b обеспечивает присоединение комплекса антиген-антитело к клеткам, обладающим рецептором этого компонента (рецептором комплемента 1, РК1), — В-лимфоцитам, эритроцитам и фагоцитам (нейтрофилам, моноцитам и макрофагам), что приводит к фагоцитозу.
Без связывания С3 с микроорганизмами нейтрофилы не проявляют фагоцитирующей функции в экспериментах in vitro. Развитие тяжелых гнойных инфекций у больных с дефицитом С3 свидетельствует о неэффективности фагоцитоза и in vivo. Активность С3b зависит от его расщепления фактором I (инактиватором С3b) с образованием iC3b, который, связываясь с рецептором iC3b (РКЗ) на фагоцитах, способствует фагоцитозу. Дальнейшая деградация iC3b фактором I и протеазами приводит к появлению C3dg, а затем и C3d. Последний связывается с РК2 на В-лимфоцитах, играя роль костимулятора индуцируемой антигеном активации В-клеток.
Видео схема классического пути активации комплемента
Редактор: Искандер Милевски. Дата обновления публикации: 18.3.2021
Система комплемента: молекулярные основы и клиническое значение

Система комплемента — комплекс белков, постоянно присутствующих в крови, которые выполняют ряд важнейших функций. На данный момент комплекс насчитывает более трех десятков белковых молекул, среди которых основные белки — С1, С2, …, С9, а также ряд белков-регуляторов. Комплемент принято относить к факторам врожденного иммунитета, выполняющим защитную функцию, однако при определенных обстоятельствах сбой работы системы комплемента может стать звеном патогенеза некоторых заболеваний.
Вначале разберем механизмы работы системы комплемента, после чего рассмотрим их клиническое значение.
Активация системы комплемента
Существует три пути активации данной системы: классический, альтернативный и лектиновый. Все они приводят к ключевому событию: формированию С3-конвертазы.
В классическом варианте комплемент активируется через IgG и IgM, которые формируют иммунные комплексы с антигенами. Комплекс С1 (состоящий из q, r и s субъединиц) связывается с Fc-фрагментом иммуноглобулина. Происходит активация C1, комплекс приобретает протеолитическую активность и активирует C4 и C2. Последние формируют ключевой ферментативный комплекс — С3-конвертазу.
При альтернативном пути активация комплемента происходит без участия антител. Инициируют его поверхностные молекулы микробов и их внеклеточные структуры — например, углеводороды, полисахариды и т. д. С3 в клетках постоянно (даже когда нет активации системы комплемента) претерпевает диссоциацию на С3а и С3b, но в очень малых количествах.
Когда в клетке появляется инициирующий фактор (предположим, это бактерия), С3b связывается с ее поверхностными молекулами. К этому комплексу присоединяются другие молекулы-регуляторы: фактор В, фактор D, пропердин. Так появляется еще одна форма С3-конвертазы.
Лектиновый путь активируется через лектин, связывающий маннозу (фактор врожденного иммунитета — MBL) или группу лектинов Ficolin, которые связывают молекулы на поверхности патогенов — дрожжей, бактерий, паразитов и вирусов. MBL и Ficolin постоянно циркулируют в крови в виде MBL-ассоциированного комплекса (MASP). Когда MASP связывается с вышеназванными молекулами, комплекс претерпевает изменения конформации и активирует уже знакомый путь C4 и C2, что приводит к формированию С3-конвертазы, как и в классическом случае.
Итак, вне зависимости от пути активации различия оканчиваются на формировании ключевого фермента — С3-конвертазы. Последняя расщепляет С3 на два фрагмента: С3а и С3b. Отметим, что С3b выполняет функцию опсонина, С3а — анафилотоксин, способный воздействовать на тучные клетки с высвобождением гистамина.
Однако С3b также способен присоединиться к С3-конвертазе и модифицировать ее, превратив в С5-конвертазу. Этот фермент проделывает то же самое с С5, образуя С5а и С5b. По аналогии, С5а — анафилотоксин, С5b — опсонин.
И снова С5b присоединяется к С5-конвертазе, вовлекая в каскад С6–С9 с формированием т. н. мембраноатакующего комплекса (MAC) [1].
.

Любой из трех путей активации системы комплемента приводит к формированию С3-конвертазы, которая расщепляет С3-компонент на С3а и С3b. Последний участвует в опсонизации патогенов и облегчает таким образом фагоцитоз, а также инициирует каскад формирования МАС. С3а вместе с С5а (и в меньшей степени С4а) — побочные продукты реакций, которые обладают провоспалительным действием («Robbins Basic Pathology», 10nd ed — 2018, p 76).
Таким образом, систему комплемента можно разделить на три функциональные группы: анафилотоксины, опсонины и мембраноатакующий комплекс — МАС.
.

Анафилотоксины
К ним относятся С3а, С4а и С5а. В целом, их роль сводится к провоспалительному действию, что выражается в повышении проницаемости сосудов микроциркуляторного русла (МЦР), вазоконстрикции. В нейтрофилах, эозинофилах и макрофагах анафилотоксины инициируют респираторный взрыв, в базофилах и тучных клетках — высвобождение гистамина. Кроме того, анафилотоксины регулируют синтез эозинофильного катионного белка, адгезию и хемотаксис эозинофилов [2].
В здоровом организме роль анафилотоксинов по большому счету этим и ограничивается. Однако в случае реакций гиперчувствительности данные молекулы могут стать ключевым звеном патогенеза. Одним из наиболее ярких примеров является бронхиальная астма.
Эпителий и гладкомышечные клетки дыхательных путей содержат рецепторы к анафилотоксинам — C3aR и C5aR. При аллергических реакциях происходит активация системы комплемента, который в свою очередь активирует иммунокомпетентные клетки (ИКК), среди которых — нейтрофилы, эозинофилы, макрофаги, дендритные клетки. Последние под влиянием стимула (например, аллергена) способны в свою очередь вновь активировать комплемент — так замыкается порочный круг.
Помимо поддержания системного воспаления, анафилотоксины ответственны и за ремоделирование дыхательных путей. Под их влиянием происходит гиперплазия мерцательного эпителия и гладкомышечных клеток, неоваскуляризация и фиброзирование паренхимы [3,4].
Также анафилотоксины играют важную роль в патогенезе синдрома системного воспалительного ответа (SIRS). При сепсисе, когда микробы в больших количествах попадают в кровоток, происходит системная активация цитокинов, хемокинов и, конечно, системы комплемента. Повышение концентрации анафилотоксинов при сепсисе, к слову, считается неблагоприятным прогностическим фактором [5].
В случае с сепсисом и SIRS анафилотоксины становятся звеном патогенеза. Наибольшая роль в данной ситуации принадлежит С5а. Предположительно, избыточный синтез этого белка приводит к дисфункции нейтрофилов, апоптозу лимфоидных клеток, способствует развитию кардиомиопатий, ДВС-синдрома и полиорганной недостаточности.
В связи с этим постепенно разрабатываются препараты, ингибирующие синтез С5а. На биологических моделях было показано, что блокада данного фактора действительно улучшает прогноз при сепсисе и SIRS [6].
МАС
Данный комплекс может формироваться на поверхности грамотрицательных бактерий и напрямую участвовать в их уничтожении (более всего действие МАС направлено против Neisseria). Описаны также случаи образования МАС на поверхности грамположительных бактерий, паразитов и мембране собственных клеток. Состоит он из последних 5 белков комплемента: С5 — С9.
Специфического рецептора, инициирующего образование комплекса, нет. Белки комплемента адгезируются на наружной поверхности клеточной стенки бактерии, после чего комплекс приобретает ферментативную активность и перфорирует мембрану. Нарушается концентрация ионов и воды — клетка погибает [7].
Недавние исследования показывают, что у МАС имеется и провоспалительное — «сублитическое» — действие. При образовании комплекса на поверхности нейтрофилов или макрофагов происходит локальная утечка провоспалительных медиаторов, а в случае атаки мезангиальных клеток и микроглии — высвобождение цитокинов. Также МАС вызывает образование инфламмасомы путем активации Nod-подобного рецептора [8].
Не допустить образование МАС на собственных клетках помогает рецептор CD59. Генетический дефект CD59 приводит к появлению пароксизмальной ночной гемоглобинурии [7]. А поскольку МАС способен поддерживать системное воспаление, он также вовлекается в патогенез различных воспалительных заболеваний (см. ниже).
Возрастная макулярная дегенерация
Возрастная макулярная дегенерация (ВМД) — основная причина слепоты у пациентов старше 50 лет в цивилизованных странах. В макуле (как и во всей сетчатке) происходят дистрофически-дегенеративные процессы, вследствие чего нарушается способность фокусировать свет в определенной точке, в результате исчезает ясность и четкость зрения. Существует две формы ВМД: влажная (быстро прогрессирующая, экссудативная) и сухая (атрофическая форма). Иногда выделяют рубцовую форму, которая скорее является завершающей стадией заболевания.
Одним из ключевых звеньев этиопатогенеза ВМД является дефект фактора комплемента H — одного из основных регуляторов системы комплемента. Функция его заключается в ингибировании С3-конвертазы (если точнее — является кофактором для протеазы, которая осуществляет катализ С3-конвертазы). Существует несколько форм гена фактора Н, один из наиболее известных — Y402H, который существенно повышает риск развития ВМД. Есть и другие, более редкие варианты [9].
В случае влажной формы ВМД происходит неоваскуляризация сетчатки — аномальное разрастание сосудов под действием VEGF (фактор роста эндотелия сосудов). В опытах было показано, что высвобождение VEGF и неоваскуляризация невозможны без действия MAC [10].
Также в обоих вариантах ВМД важная роль приписывается локальному хроническому воспалению под воздействием системы комплемента. Установлена взаимосвязь между активацией комплемента (особенно по альтернативному пути) и риском развития ВМД [10].
Разумеется, эти данные невозможно было проигнорировать, вследствие чего начали разрабатывать ингибиторы факторов системы комплемента для предотвращения ВМД. На данный момент существуют и моноклональные антитела (анти-фактор D, Экулизумаб), и рекомбинантный фактор Н, и антагонисты различных белков системы комплемента, но пока ни один из них не рекомендован для лечения ВМД [10].
Болезнь Альцгеймера
Воспалительный процесс в нервной ткани сегодня рассматривается как основное патогенетическое звено в развитии БА и других нейродегенеративных заболеваний. Также существуют данные, что прием противовоспалительных препаратов (НПВС) существенно снижает риск развития БА [11].
Однако помимо воспалительных цитокинов, важная роль в развитии локального воспаления принадлежит и системе комплемента. В ликворе пациентов с болезнью Альцгеймера обнаруживается повышенная концентрация С3 в сравнении со здоровыми пациентами. Также активность системы комплемента у пациентов с БА существенно выше [12].
Наследственный ангионевротический отек
НАО — редкое и потенциально фатальное заболевание, этиологическим фактором которого является генетический дефект (НАО 1 типа) или дисфункция (НАО 2 типа) ингибитора С1-компонента комплемента (iС1). В норме iС1 — регулятор, который блокирует весь путь активации системы комплемента. При его дефиците происходит гиперактивация начальных компонентов комплемента, следствием чего является повышение проницаемости сосудов, что приводит к различным отекам.
Проявляется НАО в основном в возрасте после 20 лет отеками конечностей, реже — шеи и лица, которые длятся 1–3, максимум — 7 дней, после чего самостоятельно проходят. Сначала пациент может их даже не замечать, однако со временем частота и выраженность отеков нарастают, может происходить отек слизистой ЖКТ, что проявляется болью, тошнотой, иногда — клиникой острого живота. Наиболее опасен отек гортани, который может сопровождаться асфиксией.
Но ситуация с лечением не так уж и плоха. Ингибитор С1 можно вводить внутривенно для профилактики приступов, для купирования — подкожно [13,14].
Пароксизмальная ночная гемоглобинурия
ПНГ — редкое заболевание, в основе которого лежит клональная экспансия гемопоэтических клеток с мутацией PIGA. Результатом данной мутации является недостаточность ГФИ-заякоренных белков, а именно — CD55 и CD59 (гликозилфосфатидилинозитол или ГФИ-якорь — гликопептид, присоединяющийся к белкам в процессе посттрансляционных модификаций).
Проявляется заболевание гемолитической анемией, костномозговой недостаточностью, тромбофилией.
В норме CD55 ингибирует С9-компонент и предотвращает формирование МАС, а CD59 — ингибирует образование С3-конвертазы и предотвращает протеолиз С3-компонента.
Патогенез начинается с внутрисосудистого гемолиза, который происходит ввиду дефицита CD55. На поверхности эритроцитов с мутацией формируется С3-конвертаза, которая запускает дальнейший синтез МАС. Образование последнего ничего не сдерживает из-за дефекта CD59. МАС перфорирует мембрану эритроцита, и клетка погибает.
Все клинические проявления — гемоглобинурия, анемия (апластическая), тромбоз/эмболия, гастроинтестинальные и неврологические симптомы, так или иначе, являются следствием данного механизма [15,16].
В качестве лечения используется трансплантация гемопоэтических клеток, гемотрансфузии, симптоматическая и поддерживающая терапия. Также достаточно перспективным является использование ингибиторов системы комплемента, например, Экулизумаба (Солириса), который, по данным некоторых публикаций, устраняет все значимые симптомы заболевания [15].
Однако по данным Кохрейна, доказательную базу Экулизумаба нельзя назвать достаточной [17].
Атипичный гемолитико-уремический синдром
Для АГУС характерными симптомами являются гемолитическая анемия, тромбоцитопения и почечная недостаточность с уремией. Этиологией данного заболевания могут быть различные генетические дефекты регуляторов системы комплемента.
Зачастую это мутация CFH, отвечающего за экспрессию уже знакомого читателю фактора Н. Таких мутаций существует более 80, они могут быть наследственными или спорадическими. Также встречаются мутации генов, ответственных за фактор В, С3-компонент комплемента, тромбомодулин и др. [18].
В лечении АГУС также может быть использован экулизумаб [19], однако и здесь ощущается нехватка доказательной базы. В основном же терапия АГУС осуществляется с помощью гемотрансфузий/плазмообмена, диализа, почечной трансплантации — и снова ни одна из названных процедур не способна избавить пациента от болезни [18]. Таким образом, наиболее перспективна разработка ингибиторов системы комплемента и проведение РКИ с их участием.
Помимо перечисленных заболеваний, система комплемента принимает непосредственное участие в патогенезе аутоиммунных кожных заболеваний [20], воспалительных заболеваний почек [21], разнообразных аллергических и аутоиммунных заболеваний.
Разработка ингибиторов комплемента уже сегодня является перспективным направлением, а некоторые препараты данной группы (экулизумаб) уже могут применяться в ряде случаев.
Читайте также:
- Острая псевдообструкция толстой кишки. Синдром Огилви.
- Гастроэзофагеальная рефлюксная болезнь (ГЭРБ). Принципы лечения рефлюксной болезни - ГЭРБ
- Раннее выявление постклимактерического остеопороза. Скрининг населения на постклимактерический остеопороз.
- Острая воспалительная демиелинизирующая полирадикулонейропатия. Лечение острой полирадикулонейропатии.
- Лечение психогенного головокружения - лекарства
